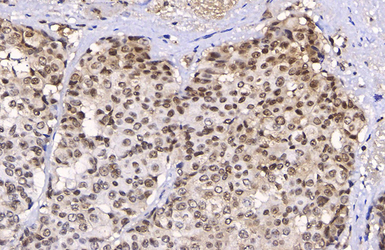
产品细节图片8

相关产品推荐更多 >
万千商家帮你免费找货
0 人在求购买到急需产品
- 详细信息
- 文献和实验
- 技术资料
- 免疫原:
Amino acids 182-582 of Mre11 expressed in E. coli.
- 亚型:
IgG1
- 形态:
Liquid
- 保存条件:
Store as concentrated solution. Centrifuge briefly prior to opening vial. For short-term storage (1-2 weeks), store at 4ºC. For long-term storage, aliquot and store at -20ºC or below. Avoid multiple freeze-thaw cycles.
- 克隆性:
Monoclonal
- 标记物:
Unconjugated
- 适应物种:
Human, Rat
- 保质期:
12 months from the shipping date of the product.
- 抗原来源:
Human
- 目录编号:
GTX70212
- 级别:
Primary Antibodies
- 库存:
Available
- 供应商:
GeneTex
- 宿主:
Mouse
- 应用范围:
WB, ICC/IF, IHC-P, IP, ELISA, Functional Assay, PLA
- 浓度:
0.45 mg/ml (Please refer to the vial label for the specific concentration.)
- 靶点:
Mre11
- 抗体英文名:
Mre11 antibody [12D7]
- 抗体名:
Mre11 抗体 [12D7]
- 规格:
100 μl

Non-transfected (–) and transfected (+) HeLa whole cell extracts (30 μg) were separated by 7.5% SDS-PAGE, and the membrane was blotted with Mre11 antibody [12D7] (GTX70212) diluted at 1:500. The HRP-conjugated anti-mouse IgG antibody (GTX213111-01) was used to detect the primary antibody.

Various whole cell extracts (30 μg) were separated by 7.5% SDS-PAGE, and the membranes were blotted with Mre11 antibody [12D7] (GTX70212) diluted at 1:1000 and competitor's antibody diluted at 1:1000. The HRP-conjugated anti-mouse IgG antibody (GTX213111-01) was used to detect the primary antibody.
*The competitor is not affiliated with GeneTex and does not endorse this product.

Mre11 antibody [12D7] detects Mre11 protein by western blot analysis.
A. 30 μg 293T whole cell extract
B. 30 μg whole cell extract of human Mre11-transfected 293T cells
7.5% SDS-PAGE
Mre11 antibody [12D7] (GTX70212) dilution: 1:1000
The HRP-conjugated anti-mouse IgG antibody (GTX213111-01) was used to detect the primary antibody.

Various whole cell extracts (30 μg) were separated by 7.5% SDS-PAGE, and the membrane was blotted with Mre11 antibody [12D7] (GTX70212) diluted at 1:500. The HRP-conjugated anti-mouset IgG antibody (GTX213111-01) was used to detect the primary antibody.

Whole cell extract (30 μg) was separated by 7.5% SDS-PAGE, and the membrane was blotted with Mre11 antibody [12D7] (GTX70212) diluted at 1:500. The HRP-conjugated anti-mouse IgG antibody (GTX213111-01) was used to detect the primary antibody, and the signal was developed with Trident ECL plus-Enhanced.

Mre11 antibody [12D7] detects Mre11 protein at nucleus by immunofluorescent analysis.
Sample: HeLa cells were fixed in 4% PFA at RT for 15 min.
Green: Mre11 stained by Mre11 antibody [12D7] (GTX70212) diluted at 1:200.
Blue: Hoechst 33342 staining.
Scale bar= 10 μm.

Various whole cell extracts (30 μg) were separated by 7.5% SDS-PAGE, and the membrane was blotted with Mre11 antibody [12D7] (GTX70212) diluted at 1:1000. The HRP-conjugated anti-mouse IgG antibody (GTX213111-01) was used to detect the primary antibody.
Mre11 antibody [12D7] detects Mre11 protein at nucleus by immunohistochemical analysis (Autostainer Formulated).
Sample: Paraffin-embedded human colon cancer.
Mre11 stained by Mre11 antibody [12D7] (GTX70212) diluted at 1:300.
Antigen Retrieval: EDTA buffer, 20 min
风险提示:丁香通仅作为第三方平台,为商家信息发布提供平台空间。用户咨询产品时请注意保护个人信息及财产安全,合理判断,谨慎选购商品,商家和用户对交易行为负责。对于医疗器械类产品,请先查证核实企业经营资质和医疗器械产品注册证情况。
 文献和实验
文献和实验Lins S et al., Gene 2009 (PMID:19635536)
Collaco RF et al., Virology 2009 (PMID:19628243)
Roques C et al., EMBO J 2009 (PMID:19609304)
Vago R et al., Cell Cycle 2009 (PMID:19597347)
Carlessi L et al., Cell Death Differ 2009 (PMID:19229246)
Zou Y et al., Mol Cell Biol 2009 (PMID:19223460)
Carson CT et al., EMBO J 2009 (PMID:19197236)
Crosby ME et al., Cancer Res 2009 (PMID:19141645)
Dery U et al., Mol Cell Biol 2008 (PMID:18285453)
Bentle MS et al., Cancer Res 2007 (PMID:17638905)
Xu M et al., Int J Hyperthermia 2007 (PMID:17558733)
Cho YW et al., J Biol Chem 2007 (PMID:17500065)
Fleisig HB et al., Oncogene 2007 (PMID:17311003)
Bekker-Jensen S et al., J Cell Biol 2006 (PMID:16618811)
Gueven N et al., Cancer Res 2006 (PMID:16540636)
Varon R et al., Hum Mol Genet 2006 (PMID:16415040)
Chai W et al., EMBO Rep 2006 (PMID:16374507)
Al Rashid ST et al., Cancer Res 2005 (PMID:16322227)
Kim JS et al., J Cell Biol 2005 (PMID:16061690)
van Veelen LR et al., Mutat Res 2005 (PMID:15914204)
Carson CT et al., EMBO J 2003 (PMID:14657032)
Uziel T et al., EMBO J 2003 (PMID:14532133)
Xu X et al., FASEB J 2003 (PMID:14519663)
Gottwein E et al., J Virol 2003 (PMID:12915562)
Lee JH et al., Mol Cancer Res 2003 (PMID:12861053)
Celeste A et al., Nat Cell Biol 2003 (PMID:12792649)
Limoli CL et al., Proc Natl Acad Sci U S A 2002 (PMID:11756691)
Harfst E et al., Mol Immunol 2000 (PMID:11282395)
Lombard DB et al., Cancer Res 2000 (PMID:10811102)
Nguyen DD et al., Sci Adv 2023 (PMID:37163605)
Saha LK et al., Nat Commun 2023 (PMID:37024461)
Thakar T et al., Nat Commun 2022 (PMID:36085347)
Dhoonmoon A et al., Nat Commun 2022 (PMID:36030235)
Kiminori Kurashima et al., NAR Cancer 2020 (PMID:34316685)
Josephine Mun Yee Ko et al., Cancers (Basel) 2021 (PMID:34572942)
Lamarche BJ et al., DNA Repair (Amst) 2019 (PMID:30583959)
Xu X et al., Nat Commun 2021 (PMID:34112784)
Dubich T et al., J Mol Med (Berl) 2021 (PMID:33484281)
Lorenson MY et al., Biol Methods Protoc 2019 (PMID:32395619)
Suzuki R et al., Nucleic Acids Res 2021 (PMID:33290559)
Yamashita R et al., Mutat Res 2020 (PMID:33198939)
Murata MM et al., Mol Biol Cell 2019 (PMID:31390283)
Bennett LG et al., Sci Adv 2020 (PMID:32832601)
Duan H et al., J Cell Biol 2020 (PMID:32391871)
Qi F et al., J Radiat Res 2020 (PMID:32211858)
Ragamin A et al., Am J Med Genet A 2020 (PMID:32212377)
Ly P et al., Nat Genet 2019 (PMID:30833795)
Volkening L et al., FASEB J 2020 (PMID:31908056)
Mooser C et al., Nat Commun 2020 (PMID:31913317)
Godau J et al., DNA Repair (Amst) 2019 (PMID:30928893)
Sohn SY et al., MBio 2019 (PMID:30808699)
Mary Y Lorenson et al., Biology Methods and Protocols 2019;4(1)
Burger K et al., Nucleic Acids Res 2019 (PMID:30668775)
Hollingworth R et al., J Virol 2017 (PMID:28855246)
Yizhou Joseph He et al., Nature 2018 (Epub)
Przetocka S et al., Mol Cell 2018 (PMID:30344097)
Fujiwara C et al., Sci Rep 2018 (PMID:30287851)
Michael Murata et al., bioRxiv 2018 (Epub)
Johnson TE et al., Cell Rep 2018 (PMID:30089259)
Cai M et al., Int J Cancer 2018 (PMID:30070702)
Shou J et al., Mol Cell 2018 (PMID:30033371)
Kong X et al., bioRxiv 2018 (Epub)
Park S et al., Mol Cancer Res 2018 (PMID:29545477)
Ahmed KM et al., Mol Cell Biol 2018 (PMID:29463647)
Mujoo K et al., Stem Cell Reports 2017 (PMID:29103969)
Taglialatela A et al., Mol Cell 2017 (PMID:29053959)
Lou J et al., Nat Commun 2017 (PMID:29042561)
Schroder-Heurich B et al., BMC Cancer 2014 (PMID:24928521)
Henrich SM et al., Sci Rep 2017 (PMID:28128338)
Smith EA et al., Sci Rep 2017 (PMID:28317934)
Bowen C et al., Cancer Res 2015 (PMID:25977336)
Markiewicz E et al., Open Biol 2015 (PMID:25924630)
Mattoo AR et al., Mol Cell Biol 2016 (PMID:27821478)
Johnson BA et al., Virology 2016 (PMID:27770701)
Lou DI et al., Cell Host Microbe 2016 (PMID:27512903)
Renaud E et al., Nucleic Acids Res 2016 (PMID:26446986)
Kozlov SV et al., Mol Cell Proteomics 2015 (PMID:26699800)
Kijas AW et al., Nucleic Acids Res 2015 (PMID:26240375)
Hollingworth R et al., Viruses 2015 (PMID:26057167)
Nakajima NI et al., PLoS One 2015 (PMID:25826455)
Harten SK et al., BMC Biol 2015 (PMID:25857663)
Huang YL et al., Hum Mol Genet 2015 (PMID:25788520)
Pathania S et al., Nat Commun 2014 (PMID:25400221)
Jian W et al., Anticancer Drugs 2014 (PMID:24714082)
Zhou Y et al., Nucleic Acids Res 2014 (PMID:24362840)
Schroder-Heurich B et al., FASEB J 2014 (PMID:24344331)
Kong X et al., Mol Cell Biol 2014 (PMID:24324008)
O'Sullivan RJ et al., Nat Struct Mol Biol 2014 (PMID:24413054)
Simoes M et al., Vet Microbiol 2013 (PMID:23398667)
Karen KA et al., J Virol 2011 (PMID:21345950)
Anderson VE et al., Cancer Res 2011 (PMID:21239475)
Matsumoto Y et al., DNA Repair (Amst) 2011 (PMID:21227757)
 技术资料
技术资料暂无技术资料 索取技术资料









![ADI1 antibody [5C2]](https://img1.dxycdn.com/2022/0328/732/2725015631988500453-14.jpg!wh200)
